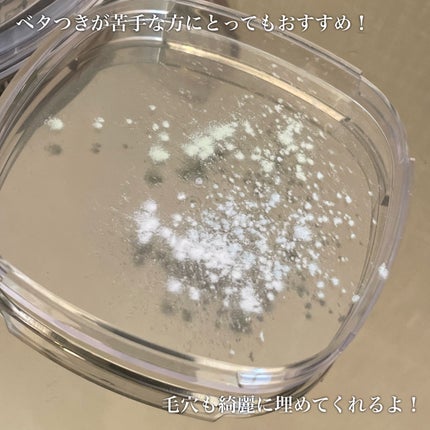
ステイフィクサーマルチカラーパウダー/wakemake/ルースパウダーを使ったクチコミ(5枚目)

3色ある事で肌の補正が出来て、粒子の細かいパウダーによって毛穴の凹凸を埋め、サラサラパウダーが油分をコントロールしてメイク崩れを防いでくれると人気の商品ですが、 ホワイト、ヌーディラベンダー、ヌーディコーラルの組み合わせがどんな肌にもムラなく華やかにカラー補正してくれる パウダー自体はマット肌のサラサラに仕上げてくれるけど、パールによってツヤ感出してくれる😘
もっと見るルースパウダーランキング
| 商品画像 | 商品情報 | 参考価格 | 評価 | ランキングIN | 特徴 | 商品リンク |
|---|---|---|---|---|---|---|
SHISEIDO SHISEIDO エッセンス スキンセッティング パウダー | 5,500円 |
| フェイスパウダーランキング第1位 | パウダーが軽いのでほんとつけていることを 忘れてしまうような薄膜感な仕上がりでした | 詳細を見る | |
GIVENCHY プリズム・リーブル | 8,250円 |
| フェイスパウダーランキング第4位 | パール配合でツヤっとした肌に✨ナチュラルなんだけど品があってこのツヤがとってもキレイなの🥺 | 詳細を見る | |
DECORTÉ ルース パウダー | 6,270円 |
| フェイスパウダーランキング第2位 | とにかくお粉がふわっふわでサラサラで良い❤️ | 詳細を見る | |
DECORTÉ フェイスパウダー | 5,500円 |
| フェイスパウダーランキング第11位 | 溢れ出るツヤ感がとっても綺麗で、透明感のある仕上がりに◎ふわりサラリと軽やかな触り心地! | 詳細を見る | |
クレ・ド・ポー ボーテ プードルトランスパラントn | 13,200円 |
| フェイスパウダーランキング第12位 | 粉の繊細さが増したと感じられファンデーションで作ったつや肌もきちんと残してくれて 「めちゃくちゃ良い…!」と心が躍りました♪ | 詳細を見る | |
ByUR セラムフィット ルースフェイスパウダー | 2,090円 |
| フェイスパウダーランキング第18位 | 顔がテカりやすく毛穴が気になる方にはぴったりです!片栗粉のようにサラッサラで、粒子がかなり細かいです✨ | 詳細を見る | |
SUQQU ザ ルース パウダー | 11,000円 |
| フェイスパウダーランキング第16位 | 細かなピンクっぽいラベンダーっぽい粒子が フワッと密着してくれて 柔らかな顔の印象になる | 詳細を見る | |
花西子 玉養桃花 ルースパウダー | 4,620円 |
| フェイスパウダーランキング第21位 | 粉を馴染ませたパフで肌を滑らせるようにするだけで陶器のようなさらさらマット肌に! | 詳細を見る | |
excel エクストラリッチ セラムインパウダー | 2,640円 |
| フェイスパウダーランキング第23位 | パフは肉厚でリッチな使用感。 ふわふわで肌あたりも良くて贅沢な使い心地..✨ パウダーは粒子が細かくてふわふわ! | 詳細を見る | |
Wonjungyo ウォンジョンヨ フィクシングブラーパウダー N | 1,980円 |
| フェイスパウダーランキング第25位 | 繊細パウダーで、ふんわりとなめらか肌に仕上げてくれます。 | 詳細を見る |
riko𖤣𖥧𖥣cosmeさんの人気クチコミ
どれもお気に入りの美容液たちなんですが、気づけばナイアシンアミド配合の美容液が多くなってしまいました、、 最近は毛穴が気になるので、積極的にビタミンCも取り入れてます😌✨ アヌアのビタCセラムは高濃度レチノールとは併用できないのでご注意を✨
もっと見る
1145
756
- 2023.11.21
韓国コスメ、fweeのリップグロス✨ 好きすぎて、また追加で購入したので手持ちのカラーをスウォッチしました💕 カラー展開がとにかく可愛くて、全色欲しくなる勢い✨ 唇が乾燥することもないし、仕上がりに立体感が出てぷるぷるになるのでおすすめです💕
もっと見る
936
451
- 2024.10.04
❤️ロムアンドベターザンアイズ1500円前後手持ちのロムアンド、スウォッチします✨いつもQoo10で、1200円程で購入しています👌01ドライマンゴーチューリップ明るさのあるコーラルオレンジ系パレット。イエベ春、ブルベ夏におすすめ✨この中で一...
もっと見る
845
317
- 2020.12.04
紫外線が気になる季節になったので、手持ちの日焼け止め乳液&下地を比較してみました🙋♀️☀️口コミで人気の日焼け止め下地、どれを買おうか悩みますよね。参考になればと思ってメモします。手持ちのファンデーションとの相性だったり、好きなテクスチャー...
もっと見る
840
243
- 2020.04.07
クリオ、プロアイパレットミニの新色。 粉質や発色の良さはそのままに、持ち運びもしやすいサイズ感で嬉しい🌷 くすんだカラーが目をひくパレット✨ パープル系でブルベさんにおすすめ! グリッターカラーのラベンダームーンがラメ好きにはたまらん♡ 使うカラーによって、ふんわり可愛くも、クールな仕上がりも楽しめる🙆♀️ 王道ブラウンパレット✨ 色の統一感があって、グラデもしやすいし、捨て色がなく、初心者さんでも失敗しない◎ パーソナルカラーはイエベさん向きですが、ブルベの私でも全然使いやすかった! クリオのアイシャドウは毎回買って損なし🙆♀️ 絶妙におしゃれなカラーが入っていて、粉質はしっとり、ラメはキラッキラで今回も、期待を裏切らないパレットでした💕
もっと見る
749
195
- 2022.02.16
私のデビューカラー。とにかく使い易くてつや感が美しい。迷ったらこれ♡ 右上のピンクに、左下のグレージュを重ねると今までにない透明感のある仕上がりに♡ 左下の赤みブラウンが大好き!一見苦手そうな右上の赤も、キワに入れると普段と違ったメイクが楽しめます♡ 全てが絶妙なカラー。プチプラにはない色味でピンクなのに大人っぽい仕上がりに♡ 去年のクリスマス限定品。息を飲む可愛さで、ブルベ大優勝のパレット♡ 美しいラメ感が楽しめるのは、30番インソレントローズで、残りはつや感が楽しめるパレットになっています😌 "諭吉アイシャドウ"との呼び名もありお値段は高いですが、プチプラにはないクオリティーなので、買う価値あると思います💕
もっと見る
724
371
- 2021.11.05
商品詳細情報wakemake ステイフィクサーマルチカラーパウダー
- ブランド名
- wakemake(ウェイクメイク)
- ランキングIN
- 全体ランキング年代別ランキングフェイスパウダー 10代 第47位フェイスパウダー 20代 第45位フェイスパウダー 30代 第45位フェイスパウダー 40代以上 第45位ルースパウダー 10代 第24位ルースパウダー 20代 第22位ルースパウダー 30代 第22位ルースパウダー 40代以上 第22位肌質別ランキング
- 容量・参考価格
- 4g: 2,750円
- バリエーション
- 01 ペールクリア
- 02 ライトスキン
- 03 サテンピンク
- 04 ペールラベンダー
- 商品説明
- わたしのベストトーンに、カラー補正※。 AIで美肌加工※ したような、なめらか肌へ。 ◆肌トーンを整えて自然に美しい仕上がりに ◆きめ細かなパウダーが毛穴をカバーしてなめらかに ◆なりたい肌に合わせた色選びが叶えられる ※メイクアップ効果による
- メーカー名
- COSMAX
- 発売日
- 2024/9/18(最新発売日: 2025/4/25)
- 成分
- <01 ペールクリア> (PURPLE) シリカ、合成フルオロフロゴパイト、(HDI/トリメチロールヘキシルラクトン)クロスポリマー、グンジョウ、1,2-ヘキサンジオール、カプリル酸グリセリル、ジメチコン、黄4 (GREEN) シリカ、合成フルオロフロゴパイト、(HDI/トリメチロールヘキシルラクトン)クロスポリマー、1,2-ヘキサンジオール、グンジョウ、カプリル酸グリセリル、ジメチコン、マンガンバイオレット、カオリン (BLUE) シリカ、合成フルオロフロゴパイト、(HDI/トリメチロールヘキシルラクトン)クロスポリマー、酸化クロム、1,2-ヘキサンジオール、カプリル酸グリセリル、ジメチコン、黄4、グンジョウ、トリエトキシカプリリルシラン <02 ライトスキン> (LAVENDER) シリカ、合成フルオロフロゴパイト、(HDI/トリメチロールヘキシルラクトン)クロスポリマー、1,2-ヘキサンジオール、カプリル酸グリセリル、ジメチコン、酸化鉄、トリエトキシカプリリルシラン (YELLOW) シリカ、合成フルオロフロゴパイト、(HDI/トリメチロールヘキシルラクトン)クロスポリマー、1,2-ヘキサンジオール、酸化鉄、カプリル酸グリセリル、ジメチコン、トリエトキシカプリリルシラン (CORAL) シリカ、合成フルオロフロゴパイト、(HDI/トリメチロールヘキシルラクトン)クロスポリマー、1,2-ヘキサンジオール、グンジョウ、カプリル酸グリセリル、ジメチコン、カオリン、酸化鉄、トリエトキシカプリリルシラン <03 サテンピンク> (SKIN) シリカ、合成フルオロフロゴパイト、酸化チタン、(HDI/トリメチロールヘキシルラクトン)クロスポリマー、1,2-ヘキサンジオール、ジメチコン、カプリル酸グリセリル、酸化スズ、酸化鉄、水酸化Al、赤226、トリエトキシカプリリルシラン (PINK) シリカ、合成フルオロフロゴパイト、酸化チタン、(HDI/トリメチロールヘキシルラクトン)クロスポリマー、1,2-ヘキサンジオール、ジメチコン、カプリル酸グリセリル、酸化鉄、酸化スズ、水酸化Al、赤226、トリエトキシカプリリルシラン (ROSY) シリカ、合成フルオロフロゴパイト、酸化チタン、(HDI/トリメチロールヘキシルラクトン)クロスポリマー、1,2-ヘキサンジオール、ジメチコン、カプリル酸グリセリル、酸化鉄、マンガンバイオレット、酸化スズ、トリエトキシカプリリルシラン、カオリン
![LIPS[リップス] - コスメのクチコミ検索アプリ](https://cdn.lipscosme.com/assets/lips_logo_full_2022-bc7b4bc9dd66035bc5696b0d16bc3d38a7be357186656c039e68cc4cf21ae675.png)

コメント